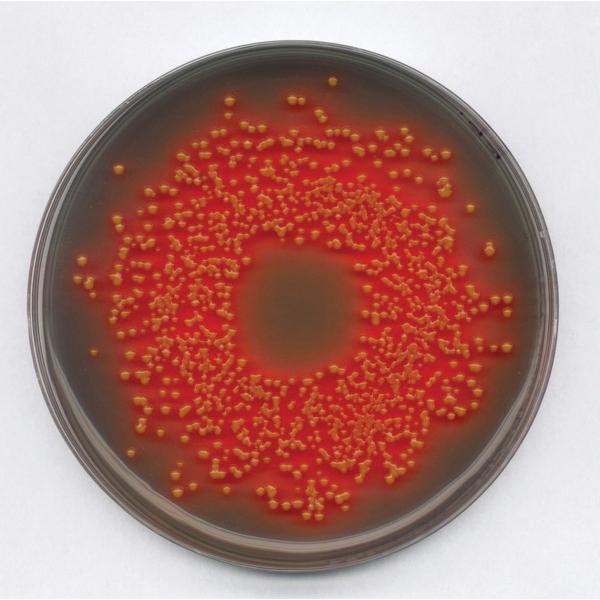
Dehydrated Microbiology Media

Culture Media
-
-

-
- Manufacturers: BD™
- Brand: Bactec™
- SECO Part No: 442193
- Sold As: Each, 50/Pack
- Manufacturer Part No: 442193
-
Availability:

- Minimum order quantity: 1
- Qty. Interval: 1
Bactec™ 442193
Plus Anaerobic/F Media, 25 ml, Liquid, 2 to 2 More...
-
Login to View Your Price
List Price :
-
Add to cart
-
-
-

-
- Manufacturers: Northeast Lab Services
- Brand: Northeast Lab Services
- SECO Part No: B2025
- Sold As: 12/Pack
- Manufacturer Part No: B2025
-
Availability:

- Minimum order quantity: 1
- Qty. Interval: 1
Northeast Lab Services B2025
Bottle, 8 oz, 90 ml Tryptic Soy Broth, With 5 More...
-
Login to View Your Price
List Price :
-
Add to cart
-
-
-

-
- Manufacturers: BD™
- Brand: Difco™
- SECO Part No: 218581
- Sold As: Each
- Manufacturer Part No: 218581
-
Availability:

- Minimum order quantity: 1
- Qty. Interval: 1
Difco™ 218581
Rappaport-vassiliadis R10 Broth, 500 g, Dehyd More...
-
Login to View Your Price
List Price :
-
Add to cart
-
-
-

-
- Manufacturers: BD™
- Brand: Falcon™
- SECO Part No: 210340
- Sold As: Each, 500/Pack
- Manufacturer Part No: 210340
-
Availability:

- Minimum order quantity: 1
- Qty. Interval: 1
Falcon™ 210340
Rodac Plate, 65 dia x 15 mm H, 10 mm Grid, 2 More...
-
Login to View Your Price
List Price :
-
Add to cart
-
-
-

-
- Manufacturers: GE Healthcare
- Brand: Whatman™
- SECO Part No: GEH-10496151
- Sold As: 50/Pack
- Manufacturer Part No: 10496151
-
Availability:

- Minimum order quantity: 1
- Qty. Interval: 1
Whatman™ 10496151
HPC Broth with TTC, 2 ml, Liquid, Ampoule, Fo More...
-
Login to View Your Price
List Price :
-
Add to cart
-
-
-

-
- Manufacturers: BD™
- Brand: Difco™
- SECO Part No: 233520
- Sold As: Each
- Manufacturer Part No: 233520
-
Availability:

- Minimum order quantity: 1
- Qty. Interval: 1
Difco™ 233520
Yeast Nitrogen Base, 100 g, Dehydrated Format More...
-
Login to View Your Price
List Price :
-
Add to cart
-
-
-

-
- Manufacturers: BD™
- Brand: Difco™
- SECO Part No: 222220
- Sold As: Each
- Manufacturer Part No: 222220
-
Availability:

- Minimum order quantity: 1
- Qty. Interval: 1
Difco™ 222220
Listeria Enrichment Broth, 500 g, Dehydrated More...
-
Login to View Your Price
List Price :
-
Add to cart
-
-
-

-
- Manufacturers: BD™
- Brand: Bacto™
- SECO Part No: 238400
- Sold As: Each
- Manufacturer Part No: 238400
-
Availability:

- Minimum order quantity: 1
- Qty. Interval: 1
Bacto™ 238400
Heart Infusion Broth, 500 g, Dehydrated Forma More...
-
Login to View Your Price
List Price :
-
Add to cart
-
-
-

-
- Manufacturers: BD™
- Brand: BBL™
- SECO Part No: 211407
- Sold As: Each
- Manufacturer Part No: 211407
-
Availability:

- Minimum order quantity: 1
- Qty. Interval: 1
BBL™ 211407
Mannitol Salt Agar, 500 g, Dehydrated Format, More...
-
Login to View Your Price
List Price :
-
Add to cart
-
-
-

-
- Manufacturers: Remel
- Brand: Oxoid™
- SECO Part No: CM0115B
- Sold As: Each
- Manufacturer Part No: CM0115B
-
Availability:

- Minimum order quantity: 1
- Qty. Interval: 1
Oxoid™ CM0115B
MacConkey Agar Number 3, 500 g, Blue, Powder, More...
-
Login to View Your Price
List Price :
-
Add to cart
-
-
-

-
GranuCult™ Lauryl Sulfate Broth, ISO, FDA-BA...
Lauryl Sulfate broth, 20 Pouches, ISO, FDA-BAM Grade, Beige, Solid, 6.8 pH, Water Soluble, +15 to +25°C Storage, Pouch Packaging
-
-
-

-
Bacto™ Dehydrated Tryptone
Tryptone, 2 kg, Dehydrated Format, Light Beige, Homogeneous Powder, 6.5 to 7.5 pH Range, 1825 Days Shelf Life, Soluble in Purified Water, 25°C Storage, Pail Packaging Type
-